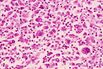
Lung cancer cells.

January 26, 2015 Issue
Opening Remarks
News - Companies & Industries
News - Companies & Industries
The CEO Who Saved a Life and Lost His Job
By Caroline Chen
YouTube Wants to Be a Super Bowl Winner, Too
By Lucas Shaw
Air China Likes Facebook for Marketing, Despite Ban
By Clement Tan
News - Technology
News - Technology
Facebook at Work Is Late to the Office
By James Tarmy
China's Streaming Fans Face a Long Wait
By Lulu Yilun Chen
Super Antibiotic: Teixobactin by NovoBiotic
By Doni Bloomfield
Features
Features
Power Hungary: How Viktor Orban Became Europe's New Strongman
By Stephan Faris
Etc.